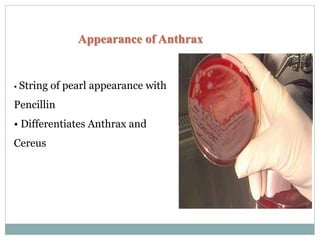
Appearance of Anthrax
• String of pearl appearance with
Pencillin
• Differentiates Anthrax and
Cereus

Anthrax is a disease caused by the bacterium Bacillus anthracis. It primarily affects herbivores like sheep, cows, and goats. Humans can be infected through contact with infected animals or soil. The bacteria forms spores that can survive for decades in the soil. There are three forms of anthrax in humans - cutaneous (skin), inhalation, and gastrointestinal. The bacteria produces lethal toxins that cause illness. Symptoms depend on the route of infection. Diagnosis involves isolating the bacteria from samples. Antibiotics like penicillin are effective if given early. Vaccination of animals can help prevent outbreaks.